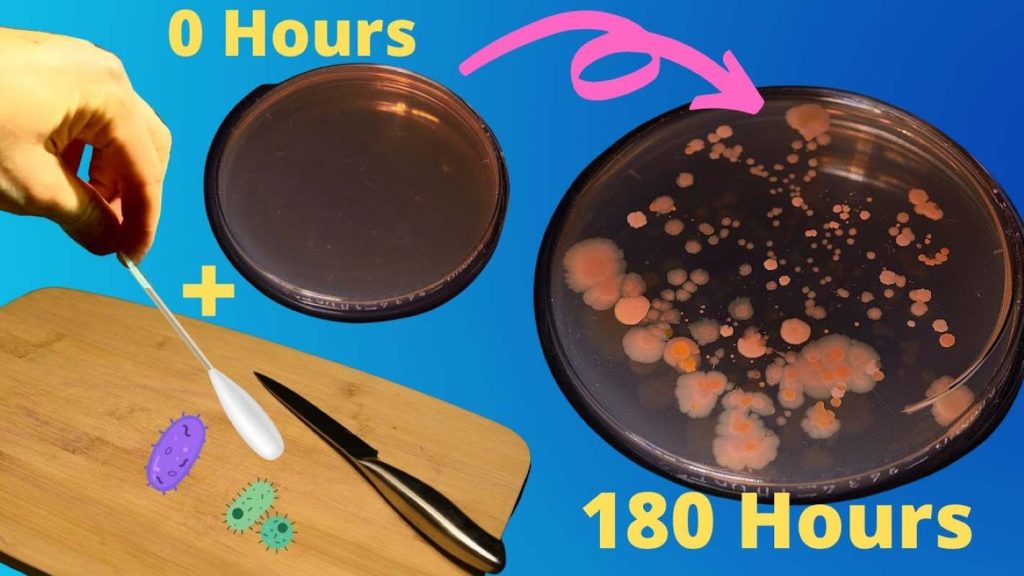
Poster for an explainer video on how to clean your Cutting Board

Not everyone pays attention to cutting board safety when shopping for the essential kitchen utensil. While scanning the utensils section of a hardware store, shoppers often struggle with deciding on the best cutting board material.
However, aside from kitchen sanitation science, the choice of cutting board material is mostly driven by personal preference. The clean, glossy finish of plastic cutting boards and their relatively low prices make this material a winner for some folks. In contrast, some die-hard fans of natural products may opt for a wooden cutting board without even understanding its pros and cons. Finding a metallic cutting board in a home kitchen could reveal whether the owner is a hobbyist or a professional chef.
Interestingly, examining cutting boards with food safety in mind may change your material preference. For instance, food microbiology tells nuanced stories about the safest cutting board material. So, get on board, as this article uses science-based evidence to evaluate the safety of cutting boards made from different materials.
Why Cutting Boards Matter for Food Safety
Meal preparations, in restaurants and even home kitchens, usually involve a lot of cutting. Cutting of onions, carrots, pepper and other veggies. Sometimes, animal products like lobster, fish, chicken, and steak also make it to the cutting board. The large variety of food, raw and ready-to-eat, that passes through the kitchen utensil in focus makes it a surface of particular concern.
Consequently, cutting boards are high-risk food-safety surfaces susceptible to cross-contamination. Imagine yourself preparing a dish that requires dicing up some farm produce, like okra and raw salmon, and using a pre-packaged salad. Cutting up these three items on a single board could expose consumers of the food to contamination risks.

One of the factors that could make cutting board safety an issue is the material the utensil is made of. For instance, wooden vs plastic cutting boards vary in the level of surface damage when exposed to the shear stress from sharp knives. The surface porosity of a cutting board directly influences its bacterial retention. This means that when boards easily accumulate knife grooves, they automatically transform into bacterial survival surfaces.
Now, you will get to compare cutting board hygiene. Subsequent sections will focus on how wood, plastic, and metal boards fare concerning contamination and sanitization.
ALSO READ: Vinegar or Baking Soda for Washing Produce: What Actually Works?
Wooden Cutting Boards: Natural but Misunderstood
A review of online purchases of wooden cutting boards suggests that premium-loving shoppers prefer hardwoods. So, cutting boards made from acacia, maple, walnut, and cherry woods are in high demand. Wooden cutting boards are also favored because they are products of natural materials. Unlike plastic and metal, cutting boards made out of wood are more forgiving on knife blades.
However, all wooden cutting boards exhibit some level of porosity. ‘Porosity’ simply means the ease with which liquid seeps through the surface or structure of a material. If you don’t want your wooden cutting board to trap juice from cut food, you may want to opt for bamboo. Cutting boards made from bamboo are very hard and less porous.
Antimicrobial Properties of Wood Cutting Boards
Between 1985 and 2024, multiple studies reveal that hardwood cutting boards showcase microbial decay. This means microbial residues that collect on wooden cutting boards tend to die off with time. Factors that easily make wooden cutting boards poor bacterial-survival surfaces are rapid dessication, antibacterial effect, and minimal dwell time. The porous structure of wood makes cutting boards made from it strip microbes of moisture.
Also, some woods contain extracts which kill microbes that come in contact with them. In a 2024 press release, the American Chemical Society revealed findings of a study on microbial retention in different wood types. The study affirms that silver birch, Scots pine, Norway spruce, and gray alder all reduce the viral activity of coronavirus. The reduction of microbial activity occurred at different times for the studied woods.

Maintenance Requirements for Wood Cutting Board Safety
- Cleaning: Avoid cleaning a wooden cutting board with a dishwasher. The sometimes long dwell time of utensils gives wood cutting boards an equivalent of soaking. Meanwhile, prolonged exposure of wooden boards may cause cracking and warping. The appropriate cleaning procedure is to hand-wash right after use, with a combination of warm water, mild soap, and a sponge or brush.
- Odor removal: If, after cleaning, unsavory odors persist, sprinkle the board with coarse salt and rub in a half-cut of lemon. Allow to stand for about 10 minutes, rinse, and dry.
- Oiling: If you bought a wooden cutting board at a premium price, you’ll definitely want it to serve you for a long time. However, how well you maintain it, not the price, determines the life span of the wooden utensil. So, Epicurious recommends conditioning wooden boards with food-grade mineral oils (not vegetable oils).
- Storage: Store wooden cutting boards upright and in a dry part of the kitchen. Exposure to dampness may cause mold growth.
- Repair: Old wooden cutting boards, with visible knife grooves, can take on new life. You only need a piece of fine-grit sandpaper and some mineral oil. Evenly sand off the grooves on the cutting board, and generously re-oil to make the utensil as good as new.
Plastic Cutting Boards: Convenient but Imperfect
From a price perspective, plastic cutting boards are about the cheapest and easiest to use. They are light-weight, safe to clean in a dishwasher, and generally non-porous when in pristine conditions. Also, due to the affordability of plastic cutting boards, you could buy a set with units that come in different colors. This could serve as a hack for designating different boards for various purposes and keeping cross-contamination in check.
That’s as far as the pros of plastic cutting boards go. Now to the cons.

Despite being affordable and having close-to-zero initial surface porosity, plastic cutting boards are noted to have short lifespans. It easily develops cut grooves that are mostly irreparable. Ignoring these deep grooves can make them prime bacterial survival surfaces.
Although plastic cutting boards are touted as safe for cleaning in a dishwasher. However, the high-density polyethylene (HDPE) commonly used in producing the utensil can get warped during high-heat sanitization.
Metal Cutting Boards: Durable but Rare
The molecules of metals are usually tightly packed, making them largely non-porous. However, not all metals qualify as food-contact materials. So, most metal cutting boards are made from either titanium or high-grade stainless steel. These two metallic materials are food-stable and possess anti-corrosive properties.
Maintaining metal cutting board hygiene is not difficult, as their surfaces are hard-wearing and easy to wash. Furthermore, the ease of cleaning reinforces its kitchen cross-contamination prevention. Lingering odors and stains are also not a challenge, so far, a metal cutting board is adequately cleaned after each use. If longevity is a deal-breaker for your choice of cutting board, then metal is the best bet.

Titanium has been established to be lighter than stainless steel. Although metal cutting boards are seldom ever victims of knife grooves, stainless steel is more susceptible to loss of lustre from scratches.
Yes, metals make superb kitchen hygiene cutting boards, but they are usually unforgiving on knives. It deadens the sharp edges of knives. Chefs with high-carbon Japanese blades are likely to avoid metal boards due to the delicate nature of these knives. Finally, there’s the case of ambiguous usability for folks who are rookies with kitchen utensils. Food may slip off the smooth surface easily. Also, metal cutting boards may generate a clanking, grating noise when not handled with poise.
Despite the metal cutting board’s safety, this variant has been adopted sparsely in home kitchens. It seems to be cut out for professional cooks.
What the Science Says About Bacteria Survival
Wooden, plastic and metal cutting boards interact with bacteria and other disease-causing microorganisms differently. However, most of these microbes show commonalities in relation to food contamination surfaces.
For instance, there is a direct correlation between the surface porosity and moisture retention of a cutting board. Wooden cutting boards are the most porous, allowing food juices and other liquids travel beyond the surface to the inner structure. Materials with relatively higher porosity naturally retain moisture for longer.
This explains why wooden cutting boards take longer to dry, in comparison to metals and plastic. However, there are special oils that create an anti-fluid layer on wood cutting boards, reducing the moisture retention. Moisture is an important growth factor in biological systems. Consequently, reducing the moisture retention of the focus kitchen utensil in turn reduces bacteria survival.
The moisture retention-surface porosity analysis offers a subtle explanation of why wooden cutting board safety requires rigorous and regular cleaning. In contrast, even light cleaning is usually effective for the sanitization of plastic (without knife grooves) and metal cutting boards. Unfortunately, low moisture retention does not automatically translate to cutting board hygiene. When handled carelessly, plastic and metal cutting boards may habor more bacteria than wood.
No matter how good a cutting board may be, it will one day reach the end of its lifespan. So, how do you know it’s time to get a new one? Splinters and warps are a surefire indicator that a wooden cutting board needs replacement. Other telltale signs that your cutting board cannot proceed as an heirloom are:
- Persistent mold growth
- Odors and stains that defy all known hacks
- Grooves that have worn deep into the material.
ALSO READ: Misleading Food Labels: How to Decode the Claims Marketers Use
So Which Cutting Board Is Actually Safest?
Having read this far, you’ve probably realized that cutting board safety is a nuanced subject. Metal, plastic, or wood do not hold all the keys to cutting board hygiene. As this piece earlier clarified, each cutting board material has its unique best use cases.

So, before buying that next cutting board, ask yourself what you are likely to use it for. For instance, if you’ll be handling a lot of raw food, attention to bacterial retention would be top priority. Overall, the kitchen hygiene of a cutting board should always take precedence over material choice.
Key Takeaway
Maintenance will play a more significant role in cutting board safety than you can imagine. Whether you buy an expensive titanium board, a cheap plastic, or a premium wood, it would become a hotbed of germs if poorly maintained. Understand the peculiarities of the cutting board material you have on your hands. Also, if possible, get a separate cutting board for raw food to avoid cross-contamination.















